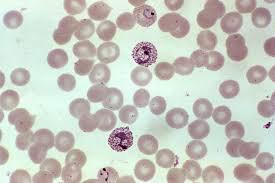
Paludisme-globules

Il ne se "trompe" pas lorsqu'il pique !
Ils étaient là bien avant nous, bien avant les dinosaures d'ailleurs, et pourtant nous ne souhaitons qu'une chose, c'est qu'ils disparaissent, ou du moins qu'ils nous laissent tranquille ; ces insectes que nous avons passé des heures à faire la chasse dans nos maisons, dont nous redoutons aussi bien le bruit caractéristique produit par leurs 200 battements d'ailes à la seconde que les maladies mortelles qu'ils peuvent transmettre.
Si vous avez l'impression d'être trop petit pour pouvoir changer quelque chose, essayer donc de dormir avec un moustique et vous verrez lequel des deux empêche l'autre de dormir
Dalaï Lama
S'il existe entre 3000 et 4000 espèces de moustiques à travers le monde, aussi bien dans les pays chauds que froids, répandus principalement autour des zones d'eau stagnante, seules les femelles (hématophages) de certaines espèces se nourrissent du sang humain dont elles ont besoin pour le développement de leurs œufs. Les mâles, eux, se nourrissent du nectar des plantes et certaines espèces femelles piqueront plutôt des animaux.

Le moustique
Comment la femelle trouve t'elle sa victime ?
Le moustique possède tout un arsenal de détection dont des yeux à facettes qui lui procurent un champ de vision très large et qui permettent également de détecter les infrarouges.
C'est en premier lieu grâce à l'odeur de la peau et à l'émission de gaz carbonique que nous dégageons lorsque nous respirons que les moustiques nous repèrent à une centaine de mètres en utilisant des récepteurs situés sur leurs antennes. Puis vers dix mètres les yeux prennent le relais pour ajuster l'approche et à un mètre c'est à nouveau les antennes qui permettent au moustique de trouver la source de chaleur et d'humidité du corps.
Pourquoi est-ce que je ne ressens pas la piqure ?
La trompe de la femelle pénètre dans la peau car elle est plus rigide et terminée par de véritables "lames". Une fois un vaisseau sanguin percé la salive du moustique est injectée avant que le sang ne soit pompé. Cette dernière contient un anesthésiant qui permet de ne presque rien ressentir et ainsi de ne pas attirer l'attention; un vasodilatateur afin d'augmenter la quantité de sang et un anticoagulant pour éviter au sang de boucher la trompe.
Pourquoi, si je ne ressens rien au départ cela me gratte, me brule, me démange par la suite ?
Cela est du à une réaction inflammatoire et des démangeaisons provoquées par la production d'anticorps par notre organisme pour combattre les corps étrangers.

Une fois le sang pompé, la femelle va pondre entre 50 et 300 œufs par ponte à la surface de l'eau. Les larves (individu qui ne ressemble pas à l'adulte qu'il va devenir et ne vit pas exactement dans le même milieu ni ne se nourrit de la même façon) se développeront en plusieurs stades avant de se transformer en nymphes puis en adultes qui vont très vite chercher un partenaire pour se reproduire et une victime à piquer en quelques jours.
Les maladies véhiculées par les moustiques
Les principales maladies vectorielles (transmises par un vecteur comme le moustique) sont :
La dengue : Transmise par le moustique de type Aedes communément appelés "tigre"; est à l'origine d'un syndrome grippal et responsable selon l'OMS de plus de 50 millions de cas dans le monde. La forme la plus sévère, la dengue hémorragique, peut faute de traitement adapté entrainer la mort de plus de 20% des personnes affectées.
Le virus Zika : Répertorié en Afrique, dans les Amériques, en Asie et dans le pacifique, transmis principalement par le vecteur de type Aedes, entraine des symptômes similaire à la dengue comme une fièvre modérée, une éruption cutanée, une conjonctivite, des douleurs musculaires et articulaires, un état de malaise ou des céphalées qui disparaissent entre 2 et 7 jours sauf complications.
Le Chikungunya : Également transmise par le moustique de type Aedes se manifeste par une forte fièvre, des maux de tête et des violentes douleurs musculaires et articulaires qui peuvent persister sur plusieurs mois.
La fièvre Jaune : Transmise par les moustiques du genre Aedes et Haemagogus en Afrique et Amérique du Sud est mortelle dans plus de 15% des cas. La vaccination est indispensable.
La fièvre du Nil occidental : Principalement issue du vecteur de type culex, passe inaperçue dans 80% des cas. Dans les autres cas un syndrome grippal avec des complications méningées peut survenir.
et le Paludisme.
Le moustique tigre (tel que Aedes albopictus) a colonisé tous les continents. Parti d'Asie du Sud-Est il a colonisé l'Océan Indien, le continent africain, l'Amérique ainsi que l'Europe par le biais de vieux pneus rapatriés pour être recyclés. Car à la différence de ses congénères le moustique tigre, que les scientifiques pensent attiré par l'odeur du caoutchouc des pneus, a cette particularité que ses œufs survivent une fois l'eau évaporée et peuvent poursuivre leur développement une fois l'eau revenue. Cette espèce est reconnaissable à ses rayures blanches sur les pattes et à la particularité de piquer en plein jour.
Le Paludisme
Dans la salive du moustique infecté (de type Anopheles) se trouvent des parasites (cinq espèces de protozoaires dont deux sont les plus dangereuses: Plasmodium vivax prédominant hors Afrique et P. falciparum le plus répandu en Afrique et le plus mortel) en forme de petits vers qui une fois inoculés vont se diriger vers le foie de la victime pour s'y métamorphoser en forme de sphère puis d'amas ressemblant à une "mûre". C'est ce changement de formes qui rend très difficile le combat par l'organisme. Une fois la "mûre" éclatée, les sphères vont se propager dans le corps et se loger dans les globules rouges où elles vont se multiplier au point de faire éclater ces dernières. Ces étapes sont en lien avec les différents symptômes ressentis, qui apparaissent généralement au bout de 10 à 15 jours (parfois des semaines) après la piqûre, se succèdent en cycles typiques alternant: vomissements, frissons, forte fièvre puis température basse et fatigue, sueurs froides et transpiration intense (accès palustre).
Toutes les formes de Paludisme ne sont pas mortelles. Quand elles le sont c'est à cause des "débris" de ces globules rouges éclatées qui s'accumulent dans le cerveau où elles peuvent boucher un vaisseau sanguin (Neuropaludisme) entrainant ainsi la victime dans un coma et une mort qui peut être très rapide.
Un moustique qui piquera la victime infectée récupère alors des parasites males et femelles qui ne pourront que se reproduire dans l'intestin de ce dernier notamment de l'espèce Anopheles gambiae sensu stricto, largement répandue dans la région afro-tropicale. De cette union vont naitre des petits vers qui se logeront dans les glandes salivaires du moustique.
L'Organisation mondiale de la santé (OMS) estime à environ 230 millions le nombre de personnes atteintes à travers le monde (91 pays confrontés à une transmission continue), notamment en Asie du Sud-Est, en Méditerranée orientale, Amérique centrale mais surtout en Afrique subsaharienne. Parmi eux un peu moins de 500 000 personnes en meurent chaque année. Les personnes les plus à risque demeurent les enfants de moins de cinq ans ainsi que les femmes enceintes. Sans traitement ou prise en charge rapidement l'infection devient mortelle.
Qu'est ce qu'on appelle Malaria ?
Si le mot Paludisme provient du Latin Paludis qui signifie "marais" les anglophones eux ont préféré le terme Malaria d'origine italienne pour décrire "le mauvais air" (mal aria) que l'on pensait jusqu'en 1897 responsable de la transmission du Paludisme/ Malaria.
Un peu d'histoire...
Si c'est un médecin militaire français du nom de Alphonse Laveran qui mit en évidence à Constantine, en 1880, l'agent de la maladie au sein des globules rouges, ce sont en revanche le professeur Ronald Ross, médecin anglais aux Indes, et Gian Battista Grassi, en Italie, qui prouvèrent à la fin du XIXe siècle que le vecteur est le moustique.
Cette maladie existerait très certainement depuis plus de 50 000 ans selon certains scientifiques. Le parasite aurait été retrouvé dans la momie de Toutankhamon ce qui pourrait suggérer que le souverain souffrait de paludisme avant sa mort.
Des symptômes qui au début sont similaires à ceux de la grippe.
Au départ on peut ressentir, et ce en fonction des formes de paludisme, une fièvre intermittente (P. falciparum: par poussées ou constante ce qui peut entrainer une erreur de diagnostique; P. vivax: cycle de trois jours de fièvre une journée sans; P. malariae: cycle de quatre jours de fièvre et une journée sans) accompagnée de frissons, céphalée, nausées, vomissements et fatigue généralisée d'intensités variées. Les conséquences dans le cadre de paludisme à P. falciparium peuvent être beaucoup plus grave surtout si aucun traitement n'est pris dans un bref délai. Les fièvres sont accompagnées de troubles de la conscience, de convulsions, anémie, hypoglycémie, sang dans les urines, défaillance de différents organes, coma et être à l'origine du décès.
Que faire pour se protéger contre le risque de piqûres ?
Si le Paludisme peut être soigné par un traitement antipaludéen qui élimine les parasites responsables il a été constaté à de nombreuses reprises une résistance aux médicaments.
L'artémisinine (principe actif d'une plante chinoise, Artemisia annua utilisée de façon traditionnelle contre le paludisme en Chine) est utilisée alors parfois en complément d'un traitement classique si le pathogène reste résistant. Les vaccins sont étudiés mais ne semblent pas assez efficaces pour le moment. En effet même si le Vaccin Mosquirix (principalement développé contre P. falciparum) fait l'objet d'une étude à grande échelle cette année dans certains pays Africains, son efficacité n'est que partielle selon certaines sources et ne sera donc qu'un outil complémentaire dans l'arsenal antipaludique et non la clé de l'éradication à ce jour. Au Mali le PfSPZ, qui contrairement au Mosquirix utilise le parasite entier vivant mais inactivé par irradiation, semble lui aussi prometteur mais les conditions de conservation et de transport entravent les essais à grande échelle (il faudra attendre 2023). Un vaccin "altruiste", également en cours de développement au Mali, permettrait de stopper la transmission du parasite et ainsi protégerait non pas les individus mais toute la communauté.
Cependant le meilleur moyen d'éviter de tomber malade reste la prévention contre les piqûres. Et dans ce domaine il y a, comme dirait notre cher moustique, à boire et à manger et les nombreux remèdes naturels ou non varient en efficacité et surtout en coût.
Si vous avez un appareil à ultraviolet ou lumière blanche chez vous qui attire beaucoup d'insectes vous pouvez le garder pour donner des couleurs d'ambiance à vos soirées mais cela s'arrêtera là car il n'attire aucunement les moustiques. Il en va de même pour ces appareils à ultrasons, pas très efficaces voir pas du tout, disons-le mais très tendance. Les bracelets anti-moustiques pourraient être efficaces si vous vous en couvrez.
Les diverses recettes de grand-mère fonctionnent parfois comme le piège à moustiques à base d'émanations de gaz, provenant de la fermentation du sucre et la levure de bière, qui attirent ces derniers; mais ces remèdes sont contraignants à réaliser et une fois de plus pas à 100% efficaces.
Le meilleur moyen de prévenir de se faire piquer reste incontestablement l'utilisation d'une moustiquaire et mieux encore une moustiquaire imprégnée, l'utilisation de répulsifs anti-moustique naturels (encens d'huiles essentielles eucalyptus citronné, citronnelle, lavande, pin) ou chimique (moins recommandés pour la santé comme ceux à base de DEET) et la pulvérisation d'insecticides même si la encore nos chers moustiques développent une certaine forme de résistance en mutant génétiquement. N'oublions surtout pas la tapette, notre outil de prédilection, que nous emmenons partout avec nous dans la maison lorsqu'une folle envie de chasse aux moustiques nous prend.
Pour être encore plus efficace et surtout parce que nous ne pouvons nous promenez sous notre moustiquaire partout où nous allons il reste l'anticipation. Éviter de laisser traîner des récipients d'eau stagnante dans notre intérieur et extérieur proche qui favoriserait le développement des larves. Éviter d'utiliser des produits cosmétiques dans les zones "fréquentées" par les moustiques qui se feront un plaisir de vous tenir compagnie toute la soirée, la transpiration et les parfums attirant ces derniers. Garder les pièces ou du moins les chambres ou les lieux de repos clos et les lumières éteintes pour ne pas les y inviter. Porter des vêtements (barrière importante) qui vous protègent en grande partie le corps et de couleur claire.
La démoustication reste également à grande échelle une méthode préventive mais les chercheurs doivent redoubler d'ingéniosité pour faire face aux remarquables capacités d'adaptation du moustique. Aux États Unis des chercheurs ont ainsi mis au point une modification génétique de moustiques mâles qui entrainerait la mort des progénitures avant que celles-ci n'atteignent l'âge adulte. Cette technique reste couteuse.
Aucune mesure n'est efficace à 100%, c'est la somme de ces mesures individuelles et collectives qui permet de diminuer la transmission.

Le MIM 2018 au Sénégal - "Deux décennies de progrès, défis et de perspectives pour mettre fin au paludisme
L'Université Cheikh Anta Diop (UCAD) a eu le plaisir d'organiser la 7ème édition du MIM (Initiative Multilatérale sur le Paludisme fondée en 1998 à Dakar) qui a pour mission de renforcer et soutenir la capacité des pays d'Afrique affectés par le paludisme dans leurs recherches en mettant en place des plateformes d'échanges et de formations. Trois mille personnes provenant de tous les continents étaient attendues du 15 au 20 Avril 2018 au CICAD (Centre International de Conférences Abdou Diouf). Si le Sénégal a été choisi pour recevoir cette Conférence Panafricaine, qui se tient tous les 3 à 4 ans, c'est grâce à son important succès dans sa lutte contre l'élimination du paludisme qui le place comme chef de file selon la publication des excellents progrès dans le rapport de l'OMS de 2017. En effet le Sénégal est réputé pour avoir diminué les cas d'infection de paludisme de 20% en 2017 en partie grâce à une nouvelle technique de dépistage développée par les hôpitaux Sénégalais dont l'hôpital Dantec où le Professeur Ndiaye Daouda (chef du service de parasitologie pharmaceutique de la FMPO en 2017) et son équipe ont développé un outil révolutionnaire ("illumigene malaria) de détection rapide et précis (test de diagnostic 80 000 fois plus sensible) du parasite dans le cadre du dépistage du paludisme.
Le paludisme est un assassin perfectionné dont il faut se protéger tant que nous ne l'aurons pas éradiqué si éradiquer nous y parvenons un jour. En attendant, malgré les efforts à travers le monde, un enfant de moins de cinq ans meurt toutes les minutes.
Let us not wait until sickness comes because health is our most valued gift
N'attendons pas de tomber malade car notre santé et notre bien-être sont les cadeaux les plus précieux que la vie puisse nous offrir